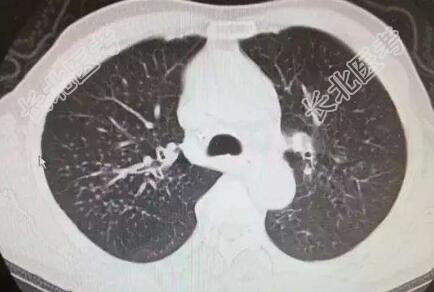

试题详情
- [材料题] 男性,68岁,退休。反复憋喘20余年,头晕下肢水肿2年,加重10天。现病史:患者既往20余年前开始出现咳嗽咳痰,胸闷气喘,好发于秋冬季节,易迁延不愈,曾在多家医院就诊,诊断为\"慢阻肺、心功能不全\",予以对症支持治疗好转出院。近2年来自感憋喘发作较前进展,并出现阵发性头晕下肢水肿,间断服药及在当地诊所输液治疗(利尿剂、抗感染、解痉平喘等),仍时有发作,近10天来受凉后再次出现胸闷气短心慌,进食及活动后明显,有咳嗽少量咳痰,白粘痰量不多,纳差乏力,头晕下肢水肿,在当地诊所输液治疗(抗感染、平喘等)效果一般,今家人为求进一步治疗,特来我院,门诊拟\"慢支\"收入我科,发病以来患者神清精神差,无头晕头痛、咯血胸痛,无偏瘫失语,无恶心呕吐,二便尚正常。
既往史:既往脑梗死高血压病10余年,遗留右侧肢体偏瘫,自服药不详。
个人史:个人及家族史无特殊
查体:T:36.2℃,P:97次/分,R:22次/分,BP:110/70/mmHg。神情精神萎,问答切题,发育正常,体型中等,呼吸稍促,推入病房,自主体位,查体尚合作,全身皮肤黏膜无黄染,浅表淋巴结未及肿大;颈静脉无怒张,头颅无畸形,双瞳孔等大等圆,直径3.0mm,对光反射灵敏;唇无紫绀,伸舌居中;颈软无抵抗,气管居中,甲状腺不大。胸廓呈桶状,肋间隙增宽,两肺呼吸音粗,可及哮鸣音及少量湿啰音,心率97次/分,律齐,各瓣膜听诊区未及明显杂音。腹平软,无包块,无压痛反跳痛,肝脾未及,肠鸣音正常无亢进,移动性浊音阴性。脊柱四肢无畸形,右侧上肢肌力3+,下肢3-,生理反射存在,双下肢水肿,双侧巴氏征(+)。
辅助检查:心电图:窦性心律,肺型P波,T波改变;心脏彩超:主动脉瓣退变伴少量反流,左室舒张功能减退;颅脑+胸部+颈部CT:双侧基底节区、丘脑、放射冠多发新陈梗塞灶,老年性脑改变,C3-4C4-5椎间盘突出,C6椎体后缘增生,右上肺结节影。

- 简答题1、该患者初步诊断为
关注下方微信公众号,搜题查看答案

- 简答题2、还需要与哪些疾病相鉴别
关注下方微信公众号,搜题查看答案

- 简答题3、如何进行治疗
关注下方微信公众号,搜题查看答案

热门试题
- 1、该患者的诊断是什么?2、如何用药治疗
- 1、请问哪种药物可长期使用,并预防夜间发
- 1、该患者初步诊断为2、还需要与哪些疾病
- 1、该患者的诊断是什么?2、如何用药治疗
- 1、请问急诊医师首先应尽快完善哪些辅助检
- 1、该患者初步诊断为2、还需要与哪些疾病
- 1、该患者的诊断是什么?2、诊断依据有哪
- 1、目前考虑的诊断是什么?诊断依据是什么
- 1、入院诊断是什么?2、最终诊断为?3、
- 1、该患者初步诊断为?诊断依据是什么?2
- 1、请问初步诊断为?(提示 血气分析:p
- 1、请问本病考虑为肺结核,但仍有怀疑。提
- 1、最可能的诊断是?2、为进一步明确诊断
- 1、该患者的诊断是什么?2、诊断依据有哪
- 1、该患者初步诊断为?2、诊断依据是什么
- 1、该患者初步诊断为?诊断依据是什么?2
- 1、请问患者初步诊断主要应考虑哪些疾病?
- 1、请问由肺癌引起的副癌综合征表现(肺癌
- 1、请问该患者进一步应做哪些检查?2、请
- 1、请问患者入院后需要积极检查辅助诊断,